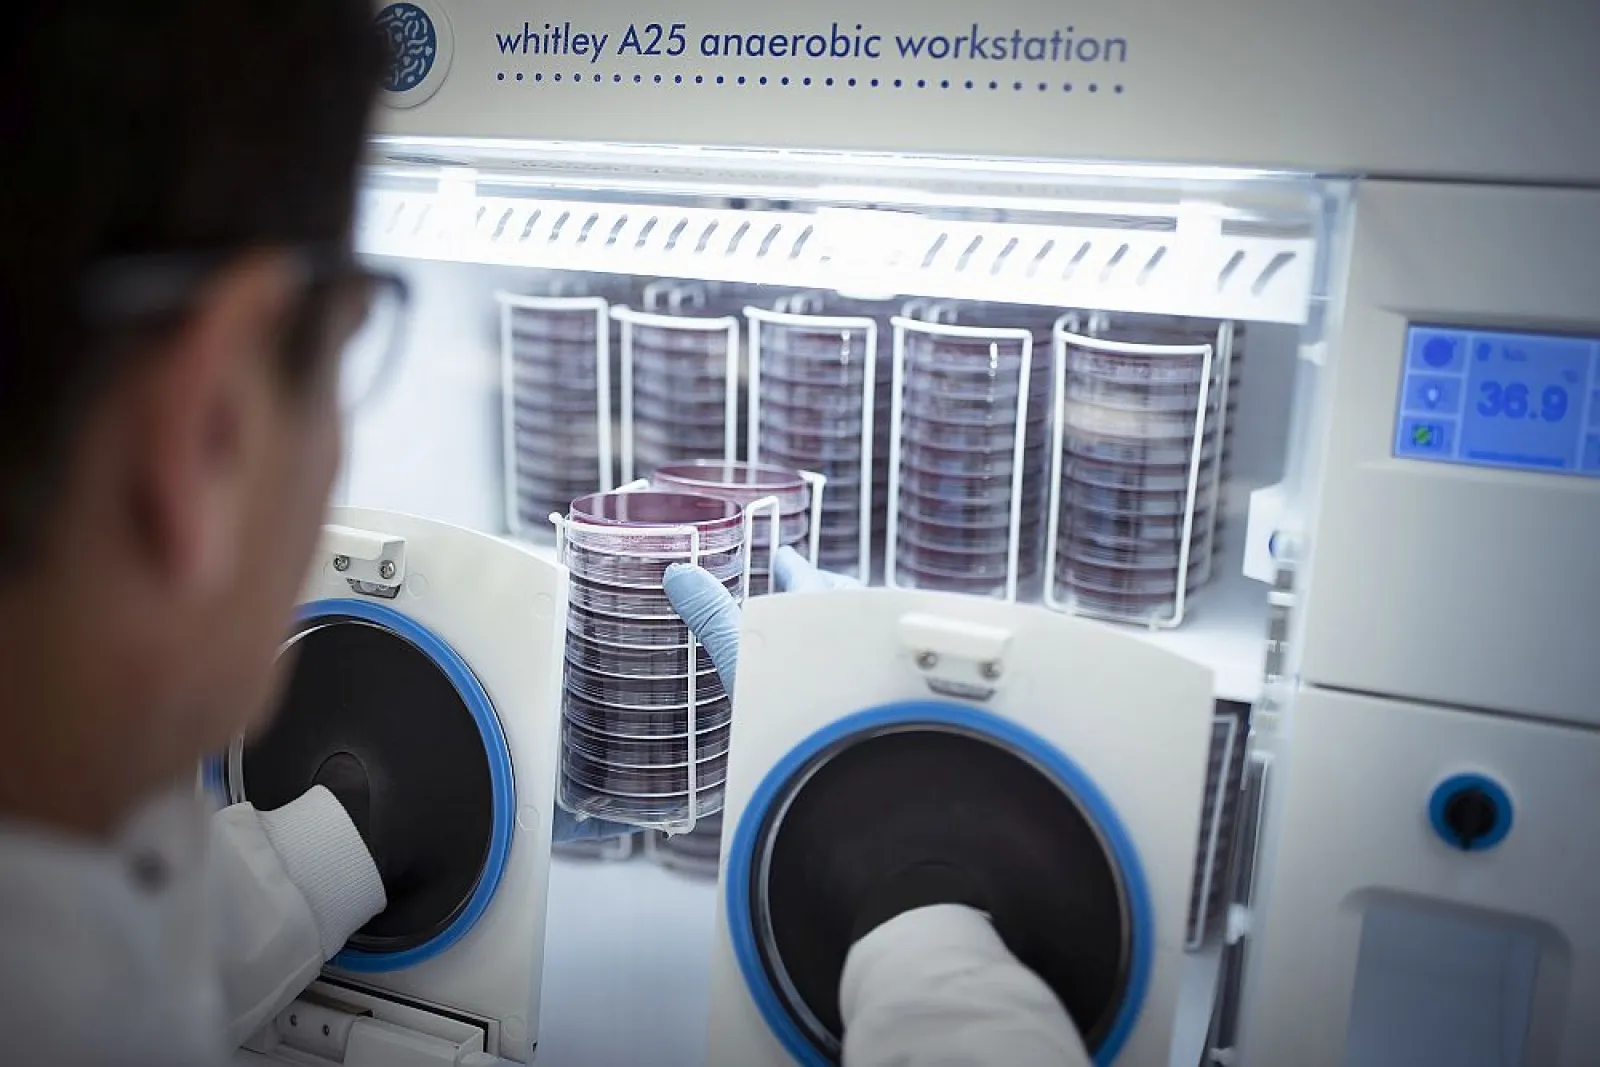

Whitley A25 Workstation
Don Whitley Scientific is proud to launch one of their most compact workstations yet, the Whitley A25 Workstation. The A25 is equipped with many unique features to ensure easy and efficient use and to guarantee that the very best anaerobic conditions are maintained. It has a capacity of 300 Petri dishes while still leaving more than adequate space to process samples in a strictly controlled anaerobic environment.
Overview
This workstation is equipped with instant access ports and has a built-in, rapid airlock that can accommodate 20 x 90mm Petri dishes or 3 x 500 ml Duran bottles. The airlock allows items to be transferred into the workstation atmosphere in 20 seconds and the doors are interlocked so cannot be opened simultaneously.
A side loading letterbox entry system is also available, providing a straightforward way to quickly introduce individual samples into the workstation. The A25 is fitted with a touch screen providing the user with an intuitive interface to control and operate the workstation.
- Previously unavailable on a workstation of this size, Whitley Workstations are the only workstations to provide automatic early warnings about the status of the anaerobic atmosphere and catalyst function.
- With a wide selection of options available, the A25 can fulfil the needs of any laboratory requiring a compact anaerobic workstation.
- A versatile instrument, the A25 can also be used as a microaerobic workstation by simply connecting the relevant pre-mixed gas.
Specifications
| Capacity Petri Dishes | 300 / 340 |
| Port Airlock Capacity | 20 x 90mm Petri dishes |
| Porthole System | Instant Access Ports or Manual Ports |
| Gas Supplies | ANO2/N2 |
| Footswitch | Wireless |
| Internal Mains Sockets | Available |
| Storage Tray | Available |
| Inspection Lamp | Available |
| Single Sample Entry | Available |
| AN02 Conditions Monitor | Available |
| Data Logging | Available |
| Airlock Cycle Time (seconds) | 20 |
| Extra Cable Glands | Available |
| Automatic Dehumidifier | Included |
| Trolley Available | Available |
| Vacuum Take Off | Available |
| Temperature Range | 5°C above ambient to 45°C |
| Touchscreen Control | Yes |
| Remote Access | Included |
| Dimensions (W/D/H mm) | 790 / 720 / 710 |
| Weight (lbs/kgs) | 163 / 74 |
Options
| A00006 | Electronic Gas Leak Detector |
| A02800 | Combined IOQ Documentation |
| A02945 | Cable Gland |
| A06102 | Vacuum Take-off Port |
| A06103 | 15cm Side Entry Letterbox |
| A06107 | Gas Sample Port |
| A06128 | Large Cable Gland |
| A06135 | Multiple Cable Port |
| A07200 | Data Logging |
| A07219 | Whitley Workstation Spotlight RH |
| A08550 | A25 Front Loading 9cm Letterbox |
| A08591 | A25 Trolley |
| A08610 | A25 Catalyst Monitoring System |
| A08611 | A25 Anaerobic Conditions Monitor |
| A08613 | A25 Power Socket |
| A09030 | Whitley A25 Workstation – Sleeved Option – 230V |
| A09031 | Whitley A25 Workstation – Sleeved Option – 110V |
| A09648 | A20/25 IP55 Splash Proof Socket Assembly |
| A09675 | Motorised Height Adjustable Trolley for 20/25 Workstations |
| A09704 | A20/25 Automatic Sleeve Gassing |
| L00040 | Temperature Mapping |
| L00050 | Single Point Temperature Calibration |

Reviews
There are no reviews yet.